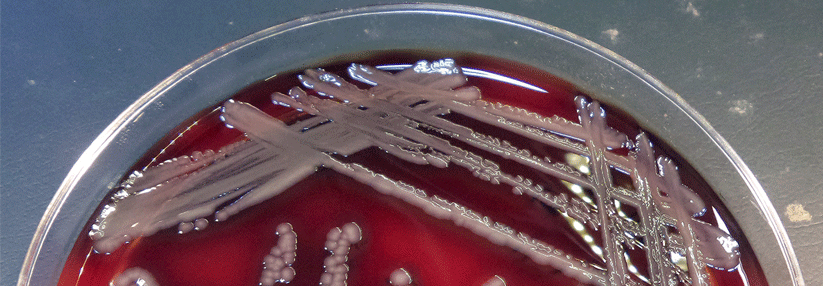

Influenza-Viren Atemwegsinfekt nach dem Hadsch
 Auch mit einer Tuberkuloseübertragung während der Pilgerfahrt ist zu rechnen.
© iStock/Aviator70
Auch mit einer Tuberkuloseübertragung während der Pilgerfahrt ist zu rechnen.
© iStock/Aviator70
Wenn Patienten mit einem Atemwegsinfekt von der Pilgerreise nach Mekka zurückkehren, sollte man auch mitten im Hochsommer an winterliche Ursachen denken. Das zeigt das Beispiel eines 49-jährigen Patienten, der im August 2019 zwei Tage nach seiner Rückkehr unter der heißen Dusche eine Synkope erlitt. Kaum aufgestanden kollabierte er erneut, kam aber selbst wieder auf die Beine.
Sein Hausarzt schickte ihn sicherheitshalber in die interdisziplinäre Notaufnahme des Helios Klinikums Bonn/Rhein-Sieg. Bei der Vorstellung dort klagte der Mann über eine leichte Belastungsdyspnoe, Husten und grünlich tingierten Auswurf. Hinzu kamen Glieder- und Rückenschmerzen sowie Übelkeit.
Die körperliche Untersuchung ergab keinen richtungsweisenden Hinweis auf die Ursache, schreiben Dr. Jan Berg und Dr. Achmad Akel aus der Bonner Klinik. Die kardiopulmonale Untersuchung blieb unauffällig, es fand sich weder ein Meningismus noch ein Exanthem und die Vitalparameter waren abgesehen von einem leichten Fieber (38,2 °C) normal. Eine Lungenembolie im Zusammenhang mit der Flugreise und der Immobilisation konnte trotz positivem D-Dimer-Test mithilfe von CT und Pulmonalisangiographie ausgeschlossen werden.
Schließlich wurde man beim Nasen-Rachen-Abstrich fündig: Die PCR auf Influenza A war positiv, das Ergebnis für MERS-Coronavirus und Influenza B negativ. Die Autoren führen die Synkopen im Rahmen der Influenza-A auf die orthostatische Belastung und die Hitzeeinwirkung während des Duschens mit konsekutiver peripherer Vasodilatation zurück.
Die Infektion mit Influenza-Viren bei einer sommerlichen Pilgerreise nach Mekka ist nicht ungewöhnlich. Denn im Gegensatz zu den gemäßigten Zonen tritt die Grippe in entsprechenden Breitengraden ganzjährig auf und sollte deshalb bei der Abklärung von Rückkehrern mit respiratorischen Symptomen primär erwogen werden. Außerdem raten die Verfasser, Teilnehmer des Hadsch möglichst schon vorab gegen Grippe zu impfen.
Auch MERS, Legionellen und Tuberkulose denkbar
Eine Infektion mit MERS-Coronaviren kommt ebenfalls als Differenzialdiagnose bei Patienten mit Fieber und pulmonalen Infiltraten nach der Mekkafahrt in Betracht. Allerdings hat diese bezüglich der islamischen Pilgerreise bisher keine wesentliche Rolle gespielt. Außerdem sollte bei allen Reiserückkehrern mit Atemwegsinfekten eine Legionellose ausgeschlossen werden. Auch mit einer Tuberkuloseübertragung während der Pilgerfahrt ist zu rechnen, diese kam aber aufgrund des kurzen zeitlichen Zusammenhangs bei dem vorgestellten Patienten nicht infrage, schreiben die Kollegen.
Quelle: Berg JP, Akel A. Flug u. Reisemed 2022; 29: 9-11; DOI: 10.1055/a-1740-9742










